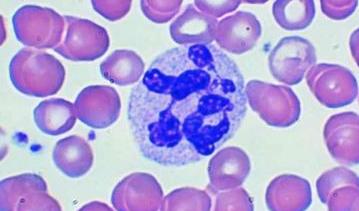

Моноциты — зрелые, крупные лейкоциты, содержащие всего одно ядро. Данные клетки являются одними из наиболее активных фагоцитов, находящихся в периферической крови. Если анализ крови показал, что моноциты повышены — у вас моноцитоз, пониженный уровень называется моноцитопенией.
Моноциты кроме крови содержатся также в больших объемах в костном мозге, селезенке, синусах печени, стенках альвеол и лимфатических узлах. В крови они находятся недолго — всего несколько дней, после чего они перемещаются в окружающие ткани, где и достигают своей зрелости. Там происходит превращение моноцитов в гистоциты — тканевые макрофаги.
Количество моноцитов является одним из самых важных показателей при расшифровке анализа крови. У взрослых повышение количества моноцитов в общем анализе крови наблюдается при самых разных недугах, отдельно рассматриваются: инфекционные, гранулематозные и кожные заболевания, а также коллагенозы, к которым относится ревматоидный артрит, системная красная волчанка, узелковый полиартрит.
Роль моноцитов в организме
Для чего нужны моноциты, что это значит? Моноциты — белые кровяные клетки, лейкоциты, которые также относятся к фагоцитам. Это означает, что они поедают проникающие в организм микробы и бактерии и таким образом избавляются от них. Но не только.
В задачу моноцитов также входит очищение «поля битвы» от других погибших лейкоцитов, благодаря чему воспаление уменьшается, а ткани начинают регенерировать.Ну и, наконец, моноциты выполняют в организме еще одну важную функцию: они вырабатывают интерферон и предотвращают развитие всевозможных новообразований.
Важным показателем в крови является соотношение моноцитов и лейкоцитов. В норме процент моноцитов к всем лейкоцитам крови составляет от 4 до 12%. Изменение этого соотношения в сторону увеличения в медицине носит название относительного моноцитоза. В отличие от этого случая возможен и рост общего числа моноцитов в крови человека. Подобное патологическое состояние медики называют абсолютным моноцитозом.
Норма
Нормы моноцитов в крови немного отличаются для взрослых и детей.
- У ребенка норма моноцитов в анализе крови составляет примерно 2-7% от общего количества лейкоцитов. При этом необходимо учитывать, что абсолютное количество моноцитов у детей с возрастом изменяется, параллельно с изменением количества лейкоцитов.
- У взрослого нормальное количество моноцитов в крови составляет 1-8% от общего количества лейкоцитов. В абсолютных числах это 0,04-0,7*109/л.
Любые отклонения от нормы в количестве моноцитов в анализе крови может говорить про наличие в организме неполадок и заболеваний.
Причины повышенных моноцитов у взрослого
Если в крови повышены моноциты у взрослого, это значит наличие моноцитоза, который бывает относительным и абсолютным. При относительном характере моноцитоза в крови снижается уровень и других лейкоцитов, а при абсолютном — увеличивается лишь число моноцитов. Причиной повышения относительного содержания клеток крови может быть нейтропения или лимфоцитопения.
Повышенный уровень моноцитов в крови может говорить о наличии:
- Инфекционных процессов, вызванных бактериями (эндокардит, туберкулез, сифилис, малярия, бруцеллез, тиф), или вирусами (мононуклеоз, гепатит);
- Некоторых болезней кроветворной системы (в первую очередь — моноцитарный и миеломоноцитарный лейкоз);
- Некоторых вполне физиологических состояний (после еды, в конце месячных у женщин, у ребенка до 7 лет и т. д.);
- Попадания в организм (чаще в дыхательные пути) веществ неинфекционной (а часто и неорганической) природы;
- Злокачественных опухолевых заболеваний;
- Коллагенозов (системная красная волчанка — СКВ, ревматизм);
- Стадии выздоровления после инфекций и других острых состояний:
- Перенесенных хирургических операций.
Повышение уровня моноцитов в крови — тревожный симптом. Он может говорить о наличии в организме воспалительного процесса, иных серьезных заболеваний. Если общий анализ крови показывает уровень моноцитов выше нормы, необходима консультация врача и дополнительное обследование, чтобы выявить причину изменений.
Повышенные моноциты у ребенка
Что это значит? Появление моноцитоза у детей также часто связано с инфекциями, особенно, с вирусными. Как известно, дети вирусными инфекциями болеют чаще взрослых, и моноцитоз при этом говорит о том, что организм берется с инфекцией.
Моноцитоз у ребенка может появляться и при глистных инвазиях (аскаридозе, энтеробиозе и так далее), после того, как гельминты будут удалены из организма ребенка, моноцитоз проходит. Туберкулез у детей в настоящее время встречается редко, тем не менее, наличие моноцитоза должно настораживать и в этом отношении.
Также причиной могут быть онкологические заболевания у ребенка — лимфогранулематоз и лейкоз.
Что делать при повышенных моноцитах?
Когда моноциты в крови повышены, лечение зависит, в первую очередь, от причины этого явления. Конечно, легче вылечить моноцитоз, который возник из-за несерьезных заболеваний, например, грибка.
Однако когда речь идет о лейкозе или раковой опухоли, лечение будет повышенное содержание моноцитов в кровидлительным и тяжелым, прежде всего, направленным не на понижение уровня моноцитов, а на избавление от главных симптомов тяжелого заболевания.
какие бы анализы не были , наш участковый врач говорит . что все хорошо, анализы хорошие. Если начинаешь возражать, она начинает психовать, и анализы по столу швырять…
Это все от незнания, поэтому лучший способ защиты это нападение
когда окончите медицинский институт и получите диплом и сертификат врача-специалиста, тогда будете комментировать поведение доктора.
А если диплом купленный? Или горе студент еле учился? Очень мало хороших специалистов, поэтому смертность высокая… Если бы их за ошибки садили, как в США, тогда бы никто не швырял карточки больных….
когда окончите медицинский институт и получите диплом и сертификат врача-специалиста, тогда будете комментировать поведение доктора.